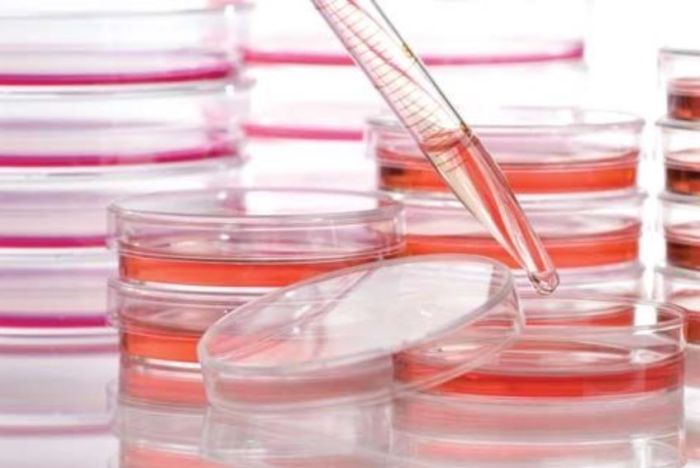
main product photo

We use cookies to make your experience better. Read more
16 x 15 mm Tissue Culture Dishes, Suspension Cultures
In stock
SKU
191-3001
$145.00
Non-pyrogenic
Crystal-grade polystyrene
Distortion-free microscopic visualization of cells
Gamma irradiation sterilized
500 / Case
Features:
Crystalgen Cell Culture Dishes are designed for optional gas exchange. A vacuum gas plasma treatment permanently and consistently modifies the cell growth surface. Stackable for easier handling.
Standard Tissue Culture Dishes
Standard tissue culture surface is hydrophilic and contains a variety of negatively charged functional groups that support cell attachment and spreading.
Packaged in sleeves of 20.
Cell Plus Tissue Culture Dishes
Cell Plus growth surface is designed for particularly sensitive adherent cells (e.g. primary cells, sensitive cell culture lines and cells which are cultivated under serum-reduced/serum-free conditions).
Suspension Tissue Culture Dishes
Suspension growth surface is a hydrophobic surface particularly suitable for the cultivation of suspension cells and minimizes cell losses during the sub-cultivation due to unwanted micro-adhesion.
| Product Name | 16 x 15 mm Tissue Culture Dishes, Suspension Cultures |
|---|---|
| SKU | 191-3001 |
Write Your Own Review
There is no safety sheet available for this product